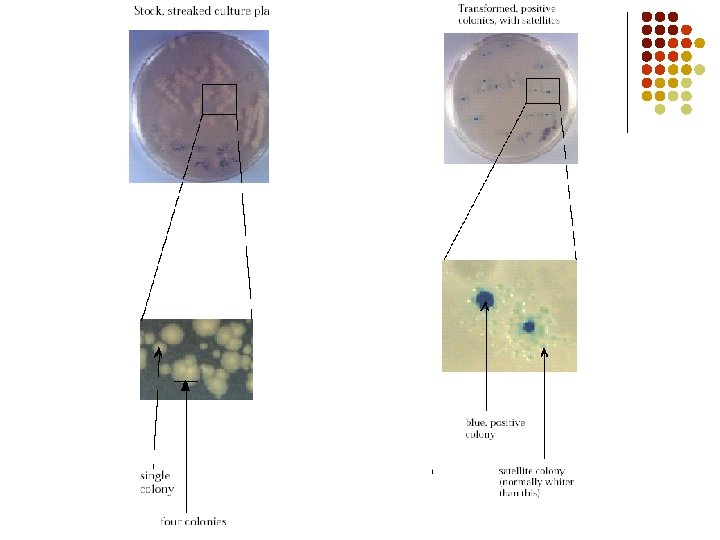

Bacterial Transformation What is transformation l Changing the

Bacterial Transformation

What is transformation? l Changing the genes and phenotype of a bacteria by uptake of foreign/new DNA l Let’s review bacterial DNA first…

Bacterial genome l Bacteria are prokaryotes—no nucleus. l l The area where DNA is located is called the nucleoid DNA is organized in one double stranded circular molecule


What is carried on the Plasmid? l l l The plasmid contains genes necessary for survival and can be passed from one bacteria to another Color Marker gene- Betagalactosidase-produces enzyme that breaks down lactose Antibiotic Resistance: Some bacteria have genes coding for enzymes that destroy certain antibiotics!

p. BLU plasmid B-galactosidase gene Ampicillin resistance gene

The transformation lab… l Our plasmid—p. Blu plasmid RNA l l Into E. coli (scary? …no!) Our plasmid contains genes for: l l Enzyme that breaks down XGal to make Indo. Blu amp= ampicillin (an antibiotic) resistance Beta-galactosidase-an enzyme that converts XGal Indo Blu Protein that allows for antibiotic resistance RNA


How do we get the plasmid inside of the bacteria? 1. Obtain E. Coli bacteria cells + Add to Ca. Cl 2 (helps plasmid attach to bacteria) 2. Add plasmid to same microtube 1. E. Coli 2. p. Blu plasmid


How do we get the plasmid inside the bacteria? l Wait…and then 3. Heat shock! This temporarily opens pores to allow the plasmid to enter the bacteria…timing is critical!!!

Growing the bacteria l After they have received the plasmid… l Placed on a growth media and allowed to grow.

How will we know if the bacteria actually got the plasmid? ? l Any ideas? l We can grow the bacteria on a plate: l l l That contains ampicillin and X-Gal Regular bacterial medium What do you predict will happen in each?

What will we observe? ? ? Predict p. Blu (+/-plasmid) LB p. Blu (+ plasmid) LB/AMP p. Blu (- plasmid) LB/AMP /X-gal
- Slides: 15